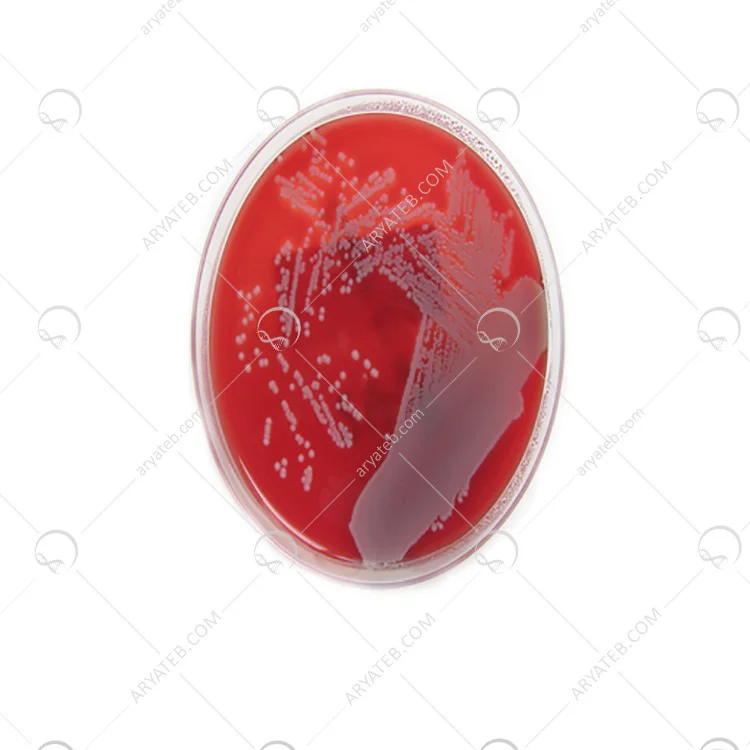

محیط کشت actinomyces agar
- برای کشت و نگهداری گونه های بی هوازی
- اکتینومایستها نوعی باکتری گرم مثبت هستند
- از تنوع شیمیایی و مورفولوژیکی خاصی تشکیل شده اند.
محیط کشت ACTINOMYCES AGAR
محیط کشت Actinomyces Agar محیطی است که برای کشت و نگهداری گونه های بی هوازی Actinomyces استفاده می شود. اکتینومایستها نوعی باکتری گرم مثبت هستند که از تنوع شیمیایی و مورفولوژیکی خاصی تشکیل شده اند.
محیط کشت Actinomyces Agar چیست
اکتینومایستها نوعی از باکتریهای گرم مثبت هستند که از نظر تنوع شیمیایی و مورفولوژیکی تشکیل می شوند ، اما در طول تکامل موجوداتی از اشکال کوکوئیدی و پلئومورفی گرفته تا رشته های شاخه ای شکل می گیرند. اکتینومایست ها جزء لاینفک خاک ، آب و گیاهان می باشند. توسعه اکتینومایست ها منجر به تشکیل متابولیت های فرار می شود که اثرات آنها برای انتقال بوی نامطبوع آب یا طعم گل آلود به ماهی کافی است. Actinomycetes همچنین قادر به تولید فوم غلیظ در فرآیند لجن فعال با رشد بسیار می باشد که در تصفیه فاضلاب اختلال ایجاد می کند. از محیط Actinomyces Agar برای پرورش و نگهداری گونه های بی هوازی Actinomycetes استفاده می شود. برای گیاهان توصیه می شود. مواد جامد تزریق شده HM B ، تریپتوز ، تریپتون ، عصاره مخمر ، نشاسته و دکستروز به عنوان منابع کربن ، نیتروژن ، گوگرد ، ویتامین ها و سایر عوامل رشد. نمک های فلزی الکترولیت ها و مواد معدنی ضروری برای محیط زیست را تأمین می نمایند.
ترکیبات محیط کشت Actinomyces Agar

دستورالعمل آماده سازی محیط کشت Actinomyces Agar
- 77.22 گرم را در 1000 میلی لیتر آب تصفیه شده / مقطر معلق کنید.
- محلول را گرم کنید تا محیط به صورت کامل حل گردد.
- سپس در یک لوله یا یک بطری توزیع کنید.
- با اتوکلاو در دمای 151 درجه سانتی گراد به مدت 15 دقیقه استریل کنید
آدرس ایمیل شما منتشر نخواهد شد. فیلدهای الزامی علامت گذاری شده اند *